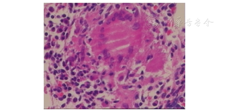

版权归中华医学会所有。
未经授权,不得转载、摘编本刊文章,不得使用本刊的版式设计。
除非特别声明,本刊刊出的所有文章不代表中华医学会和本刊编委会的观点。
患者男,52岁,于2016年2月开始无诱因出现腰部酸痛,到当地医院就诊后症状无明显改善,为进一步治疗于2016年5月6日到南方医科大学附属南方医院就诊。实验室检查:白细胞计数12.75 ×109/L,中性粒细胞比例0.765,红细胞沉降率114 mm/1 h;结核感染T淋巴细胞斑点试验(T-SPOT.TB)结果不确定;布鲁杆菌凝集试验<1︰25(阴性);降钙素原、C反应蛋白、肿瘤指标、血清免疫固定、血清蛋白电泳等未见异常。全身骨显像提示,第2、3腰椎放射性浓聚程度高;腰椎CT及MRI提示:左侧腰大肌肿胀,第2、3腰椎椎体骨质改变合并第3腰椎椎体压缩性骨折,右侧髂骨翼骨质感染性病变(图1,图2)。进一步行左侧腰大肌病理活组织检查示,未见异型细胞,见少许横纹肌及脂肪组织。骨髓涂片未见异常;骨髓活组织检查示,骨髓增生轻度低下伴少量肉芽肿结构形成(图3)。全身正电子发射计算机X线断层扫描技术(PET-CT)提示:腹部肠系膜间及腹膜后区多个淋巴结、左侧腰大肌、第2、3腰椎椎体、左侧肾上腺及全身骨骼内多个代谢增高病灶,考虑活动性结核病灶。2016年5月11日给予患者异烟肼、利福平、链霉素、吡嗪酰胺、乙胺丁醇及左氧氟沙星诊断性抗结核治疗,2016年6月6日症状改善后出院并继续抗结核治疗。

患者于2016年7月中旬出现双侧乳房增大,2016年7月28日再次入院。近1年体质量由57 kg下降至45 kg。既往史:2015年5月因右下腹痛于当地医院诊断肠套叠,行右半结肠切除术,术后病理示:炎性改变。2015年7月因发热、胸痛于当地医院诊断肺脓肿,行左胸左上肺叶切除术,术后病理示:大量纤维组织增生,多灶性化脓性炎,符合脓胸改变。体格检查:患者生命体征平稳,慢性病面容,体型消瘦,身体质量指数(BMI)=17.3 kg/m2;双侧乳房稍增大,左侧乳房区触及大小1.5 cm×1.0 cm包块,压痛阳性,活动度欠佳,与周围组织无黏连;左胸可见一长约20 cm术后瘢痕,右侧腹部可见一长约15 cm纵行手术瘢痕,左侧胸部及双侧肋骨压痛阳性;腹部平软,无压痛及反跳痛,肝、脾肋下未触及。2016年7月入院后实验室检查:白细胞计数12.52×109/L,中性粒细胞计数8.93×109/L,Hb 114 g/L;红细胞沉降率90 mm/1 h,降钙素原0.070 g/L,C反应蛋白54.7 mg/L;铁蛋白508.50 g/mL,β2-微球蛋白2.57 mg/L;真菌D-葡聚糖54.82 mg/L;卵泡刺激素48.25 IU/L(正常值1.5~12.4 IU/L),黄体生成素37.47 IU/L(正常值1.7~8.6 IU/L),催乳素42.88 g/L(正常值4.04~15.2 g/L),雌二醇、雌三醇、孕酮、睾酮、生长激素、促甲状腺素、促肾上腺皮质激素、皮质醇未见异常。乳腺B超示:左侧乳头旁9点钟位置见一1.6 cm×1.0 cm低回声区,形态不规则,边界不清楚。垂体MRI提示垂体肉芽肿性炎性反应。2016年8月3日复查PET-CT示:考虑结核或者其他感染性病变可能,其中左肺上叶、左侧腰大肌代谢相对上次(2016年5月7日)病灶稍缩小,双肺门、纵隔内、右侧膈肌脚深面、中上腹部腹膜后区多个淋巴结、吻合口后方系膜及升结肠旁系膜内多个结节及全身多次骨骼代谢相对上次增高(图4)。右侧髂骨高代谢病灶病理检查示:肉芽肿性炎伴凝固性坏死及化脓性炎,考虑结核或非典型分枝杆菌(nontuberculous mycobacteria,NTM)感染(图5)。病理组织培养示:无细菌生长。入院继续予抗结核治疗,患者症状无明显缓解,考虑NTM可能性大,予经验性加用克拉霉素治疗,建议患者进一步行组织涂片、培养及PCR明确病原学,患者拒绝,带药出院继续治疗。2017年6月12电话随访患者全身无明显疼痛,症状明显好转。


注:全身多处高代谢病灶,考虑结核或其他感染性病变(标准摄取最大值为18,平均值为3.6~6.8)


NTM是除了结核分枝杆菌复合群和麻风分枝杆菌以外的其他分枝杆菌,与结核分枝杆菌类似,属于需氧菌,具备抗酸染色特点。迄今为止,共发现NTM菌种154种和13个亚种,大部分为腐生菌,致病菌仅20余种。NTM广泛存在于自然界中,以土壤和水中最多见[1],人和动物均可感染,但尚未发现人与人之间传播证据[2]。近年来,由于艾滋病的流行及相应的检测方法的提高,NTM感染所占的比例将逐步提高。有文献报道,大多数工业化国家NTM病的发病率为1/10万~1.8/10万[3],我国1979年第1次全国结核病流行病学调查NTM分离率为4.3%,到2010年已经上升为22.9%,表明我国NTM感染和发病总体上呈现逐渐增多的趋势[4]。
与结核分枝杆菌相比,NTM毒力和致病性均较低,通常属于机会性致病菌,大多数患者有慢性基础疾病或免疫损害[5]。NTM感染具有与结核病临床表现相似的全身中毒症状和局部损害表现,最主要表现为肺部,其次为淋巴结、骨骼、关节、皮肤和软组织等,对于免疫抑制的患者容易引起全身播散性疾病,危及生命[6]。NTM的病理与结核病很难鉴别,区别在于NTM感染的干酪样坏死较少。不同种类致病菌,其病理表现可在急性化脓性炎性反应和典型的肉芽肿性炎性反应之间变化。确诊NTM感染金标准仍是病原学检查,确诊后仍需行NTM菌种鉴定及药物敏感试验,以制定个体化化学治疗方案。治疗原则为尽早行病原菌检查及菌种鉴定、药物敏感试验,选择恰当、敏感的抗菌药物,早期、联合、适量、规则、全程使用抗结核药物治疗,目前多主张5~6种药联合治疗,强化期6~12个月,巩固期12~18个月,在抗酸杆菌阴转后继续治疗至少12个月,必要时药物治疗联合外科手术治疗[7,8]。
本例患者为慢性病史,主要表现为1年前因腹痛行右半结肠切除术,2个月后因胸痛、发热行左上肺叶切除术,术后出现腰痛及全身酸痛不适,病变累及呼吸、消化系统、淋巴组织、骨组织、软组织等多部位,第1次入院时考虑结核并予正规抗结核治疗3个月后疼痛症状未见明显好转。实验室检查T-SPOT.TB结果未确定,抗结核治疗后多次查外周血白细胞计数、红细胞沉降率仍升高。影像学上,复查PET-CT示多部位淋巴结、骨骼等高代谢病灶未见减小。病理上,肠切除及左上肺叶切除术后病理提示慢性炎性反应、化脓性炎性反应改变,骨髓活组织检查未见干酪样坏死,右侧髂骨病理示肉芽肿性炎伴凝固性坏死及化脓性炎,病理上均未见典型结核病理改变。多次行组织病理学培养均阴性。综合考虑慢性化脓性炎性反应改变明确,但病原学不明,经正规抗结核治疗3个月后疗效不明显,结核依据不足,不除外非结核分枝杆菌可能,经验性加用克拉霉素治疗,出院后长期随访患者规律服药,1年后症状明显缓解,进一步验证NTM感染的可能。
本病例欠缺之处在于最终未获得明确的病原学依据,曾多次建议患者于高代谢病灶处行组织涂片、培养及PCR等检查,但患者均未同意。由于NTM菌种不同治疗方案及时间不同,本病例无法依据菌种及药物敏感试验制定个体化治疗方案。但提示临床上在排除其他疾病考虑非结核分支杆菌感染时,可经验性治疗,并密切随访患者,进一步验证诊断。
除了疼痛症状外,患者第2次入院出现双侧乳房稍增大伴压痛,B超提示乳腺低回声区,考虑男性乳腺发育症可能。男性乳腺发育症是由于生理性或病理性等因素引起男性体内雌激素与雄激素比例失调而导致的乳房组织异常发育、乳腺结缔组织异常增生的一种疾病,通常表现为单侧或双侧乳房触痛性肿块或乳房无痛性进行性增大。主要分为生理性、病理性、药物性、特发性,其中药物性可见于利血平、异烟肼、洋地黄、氯丙嗪、安体舒通、长春新碱等[9,10]。患者为中年男性,出现双侧乳房发育症状仅1个月余,生理性、特发性依据不足。睾酮、性功能正常,睾丸功能病变如睾丸功能减退、睾丸肿瘤引起依据不足。促肾上腺皮质激素、皮质醇正常,肾上腺疾病如肾上腺肿瘤引起依据不足。虽然垂体MRI示肉芽肿性炎性反应可能,但生长激素、促肾上腺皮质激素、催乳素、甲状腺功能未见异常,提示垂体功能变化不大,垂体病变如垂体肿瘤、垂体炎引起乳腺发育依据不足。患者既往无甲状腺疾病、肝硬化、肾功能衰竭等病史,乳房增大出现在服用结核药物后,最终考虑异烟肼引起男性乳腺发育。也有文献报道异烟肼可引起乳腺发育[9,11]。异烟肼引起乳腺发育具体作用机制尚不明确,一般停药后可自行缓解[11]。
综上所述,通过本病例提高临床医师对结核和非结核分枝杆菌认识,两者由于临床表现、实验室检查、影像学检查及病理检查相似,诊断上容易出现误诊。临床上经抗结核效果不明显时需要考虑非结核分枝杆菌可能,并应该积极多途径寻找到病原学依据,行菌种鉴定及药物敏感试验结果制定个体化化学治疗方案,在找不到病原学时,可考虑诊断性治疗,长期随访患者。对于抗结核后乳腺增生患者,临床医师应注意异烟肼引起男性乳腺增生可能。





















